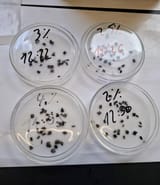

Anonymous
8/22/2025, 12:55:28 PM
No.64155555
[Report]
>>64155557
>>64155718
>>64156018
>>64156022
>>64157009
>>64157534
cleaning & lubing thread
you clean your guns lately?
the other day ago i cleaned an AK and a 22lr revolver which both haven't been cleaned in a few years
there was no damage at all, just carbon, still shouldn't have left it that long though
also got some surface rust off a west german sig
those pistols have terrible finishes, they rust at the drop of a hat, what were they thinking?
the other day ago i cleaned an AK and a 22lr revolver which both haven't been cleaned in a few years
there was no damage at all, just carbon, still shouldn't have left it that long though
also got some surface rust off a west german sig
those pistols have terrible finishes, they rust at the drop of a hat, what were they thinking?